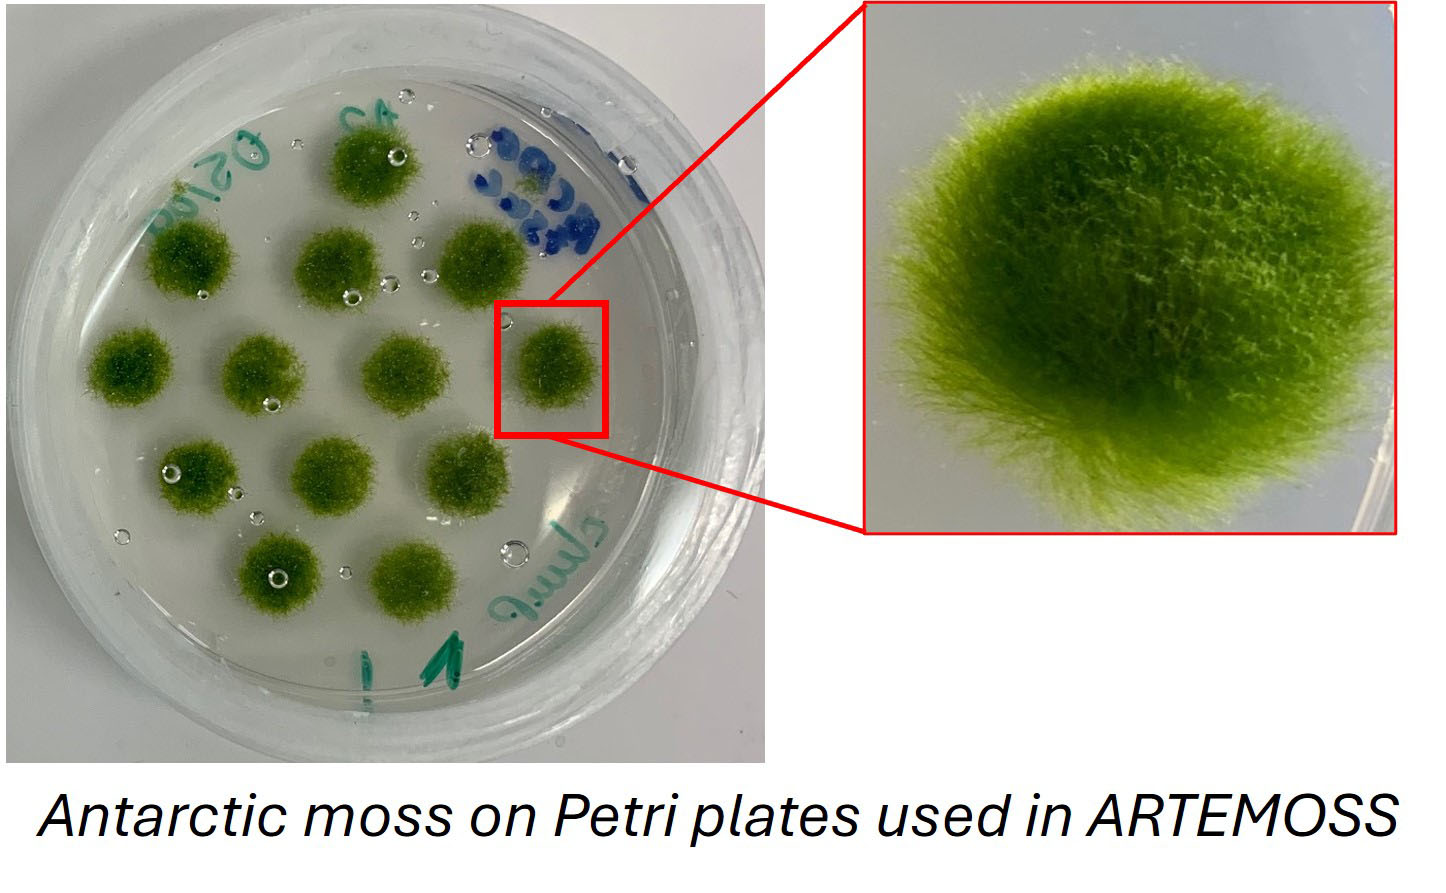

New science experiments for NASA are set to launch aboard the agency’s SpaceX 31st commercial resupply services mission to the International Space Station. The six investigations aim to contribute to cutting-edge discoveries by NASA scientists and research teams. The SpaceX Dragon spacecraft will liftoff aboard the company’s Falcon 9 rocket from Launch Complex 39A at NASA’s Kennedy Space Center in Florida.
5.10.2024
NASA Invites Media to SpaceX’s 31st Resupply Launch to Space Station

Media accreditation is open for the next launch to deliver NASA science investigations, supplies, and equipment to the International Space Station. This launch is the 31st SpaceX commercial resupply services mission to the orbital laboratory for the agency and will lift off on the company’s Falcon 9 rocket.
NASA and SpaceX are targeting no earlier than Wednesday, Oct. 30, to launch the SpaceX Dragon spacecraft from Launch Complex 39A at NASA’s Kennedy Space Center in Florida.
Credentialing to cover prelaunch and launch activities is open to U.S. media. The application deadline for U.S. citizens is 11:59 p.m. EDT, Tuesday, Oct. 15. All accreditation requests must be submitted online at:
Credentialed media will receive a confirmation email upon approval. NASA’s media accreditation policy is available online. For questions about accreditation, or to request special logistical support, email: ksc-media-accreditat@mail.nasa.gov. For other questions, please contact NASA’s Kennedy Space Center newsroom at: 321-867-2468.
Para obtener información sobre cobertura en español en el Centro Espacial Kennedy o si desea solicitor entrevistas en español, comuníquese con Antonia Jaramillo o Messod Bendayan a: antonia.jaramillobotero@nasa.gov o messod.c.bendayan@nasa.gov.
Each resupply mission to the station delivers scientific investigations in the areas of biology and biotechnology, Earth and space science, physical sciences, and technology development and demonstrations. Cargo resupply from U.S. companies ensures a national capability to deliver scientific research to the space station, significantly increasing NASA’s ability to conduct new investigations aboard humanity’s laboratory in space.
In addition to food, supplies, and equipment for the crew, Dragon will deliver several new experiments, including the Coronal Diagnostic Experiment, to examine solar wind and how it forms. Dragon also delivers Antarctic moss to observe the combined effects of cosmic radiation and microgravity on plants. Other investigations aboard include a device to test cold welding of metals in microgravity, and an investigation that studies how space impacts different materials.
Crews have occupied the space station continuously since November 2000. In that time, 280 people from 23 countries have visited the orbital outpost. The space station is a springboard to NASA’s next great leap in exploration, including future missions to the Moon under Artemis, and ultimately, human exploration of Mars.
Quelle: NASA
----
Update: 26.10.2024
.
NASA Science on Health, Safety to Launch on 31st SpaceX Resupply Mission
Science experiments aboard the spacecraft include a test to study smothering fires in space, evaluating quantum communications, analyzing antibiotic-resistant bacteria, examining health issues like blood clots and inflammation in astronauts, as well as growing romaine lettuce and moss in microgravity.
Developing Firefighting Techniques in Microgravity
Putting out a fire in space requires a unique approach to prioritize the safety of the spacecraft environment and crew. The SoFIE-MIST (Solid Fuel Ignition and Extinction - Material Ignition and Suppression Test) is one of five investigations chosen by NASA since 2009 to develop techniques on how to contain and put out fires in microgravity. Research from the experiment could strengthen our understanding of the beginning stages of fire growth and behavior, which will assist in building and developing more resilient space establishments and creating better plans for fire suppression in space

Combating Antibiotic Resistance
Resistance to antibiotics is as much of a concern for astronauts in space as it is for humans on Earth. Research determined that the impacts of microgravity can weaken a human’s immune system during spaceflight, which can lead to an increase of infection and illness for those living on the space station.
The GEARS (Genomic Enumeration of Antibiotic Resistance in Space) investigation scans the orbiting outpost for bacteria resistant to antibiotics and these organisms are studied to learn how they thrive and adapt to microgravity. Research results could help increase the safety of astronauts on future missions as well as provide clues to improving human health on Earth.

Understanding Inflammation and Blood Clotting
Microgravity takes a toll on the human body and studies have shown that astronauts have had cases of inflammation and abnormally regulated blood clotting. The MeF-1 (Megakaryocytes Orbiting in Outer Space and Near Earth: The MOON Study (Megakaryocyte Flying-One)) investigation will conduct research on how the conditions in microgravity can impact the creation and function of platelets and bone-marrow megakaryocytes. Megakaryocytes, and their progeny, platelets, are key effector cells bridging the inflammatory, immune, and hemostatic continuum.
This experiment could help scientists learn about the concerns caused by any changes in the formation of clots, inflammation, and immune responses both on Earth and during spaceflight.

Building the Space Salad Bar
The work continues to grow food in the harsh environment of space that is both nutritious and safe for humans to consume. With Plant Habitat-07, research continues on ‘Outredgeous’ romaine lettuce, first grown on the International Space Station in 2014.
This experiment will sprout this red lettuce in microgravity in the space station’s Advanced Plant Habitat and study how optimal and suboptimal moisture conditions impact plant growth, nutrient content, and the plant microbiome. The knowledge gained will add to NASA’s history of growing vegetables in space and could also benefit agriculture on Earth.

Mixing Moss with Space Radiation
ARTEMOSS (ANT1 Radiation Tolerance Experiment with Moss in Orbit on the Space Station) continues research that started on Earth with samples of Antarctic moss that underwent simulated solar radiation at the NASA Space Radiation Lab at Brookhaven National Lab in Upton, New York.
After exposure to radiation some of the moss samples will spend time on the orbiting outpost in the microgravity environment and some will remain on the ground in the 1g environment. ARTEMOSS will study how Antarctic moss recovers from any potential damage from ionizing radiation exposure when plants remain on the ground and when plants grow in spaceflight microgravity. This study leads the way in understanding the effects of combined simulated cosmic ionizing radiation and spaceflight microgravity on live plants, providing more clues to plant performance in exploration missions to come.
Enabling Communication in Space Between Quantum Computers
The SEAQUE (Space Entanglement and Annealing Quantum Experiment) will experiment with technologies that, if successful, will enable communication on a quantum level using entanglement. Researchers will focus on validating in space a new technology, enabling easier and more robust communication between two quantum systems across large distances. The research from this experiment could lead to developing building blocks for communicating between equipment such as quantum computers with enhanced security.

NASA’s Biological and Physical Sciences Division pioneers scientific discovery and enables exploration by using space environments to conduct investigations not possible on Earth. Studying biological and physical phenomenon under extreme conditions allows researchers to advance the fundamental scientific knowledge required to go farther and stay longer in space, while also benefitting life on Earth.
Quelle: NASA
----
Update: 1.11.2024
.
NASA Sets Coverage for SpaceX 31st Station Resupply Launch, Arrival

NASA and SpaceX are targeting 9:29 p.m. EST, Monday, Nov. 4, for the next launch to deliver science investigations, supplies, and equipment to the International Space Station. This is the 31st SpaceX commercial resupply services mission to the orbital laboratory for the agency.
Filled with nearly 6,000 pounds of supplies, a SpaceX Dragon spacecraft on a Falcon 9 rocket will lift off from Launch Complex 39A at NASA’s Kennedy Space Center in Florida.
Live launch coverage will begin at 9:10 p.m. on NASA+ and the agency’s website. Learn how to watch NASA content through a variety of platforms, including social media.
NASA’s coverage of arrival will begin at 8:45 a.m. Tuesday, Nov. 5, on NASA+ and the agency’swebsite. Dragon will dock autonomously to the forward port of the space station’s Harmony module.
In addition to food, supplies, and equipment for the crew, Dragon will deliver several new experiments, including the Coronal Diagnostic Experiment, to examine solar wind and how it forms. Dragon also delivers Antarctic moss to observe the combined effects of cosmic radiation and microgravity on plants. Other investigations aboard include a device to test cold welding of metals in microgravity, and an investigation that studies how space impacts different materials.
Media interested in speaking to a science subject matter expert should contact Leah Cheshier at: leah.d.cheshier@nasa.gov.
The Dragon spacecraft is scheduled to remain at the space station until December when it will depart the orbiting laboratory and return to Earth with research and cargo, splashing down off the coast of Florida.
NASA’s mission coverage is as follows (all times Eastern and subject to change based on real-time operations):
Monday, Nov. 4:
3:30 p.m. – Prelaunch media teleconference (no earlier than one hour after completion of the Launch Readiness Review) with the following participants:
- Bill Spetch, operations and integration manager, NASA’s International Space Station Program
- Meghan Everett, deputy chief scientist, NASA’s International Space Station Program
- Jared Metter, director, flight reliability, SpaceX
Media who wish to participate by phone must request dial-in information by 5 p.m. Friday, Nov. 1, by emailing Kennedy’s newsroom at: ksc-media-accreditat@mail.nasa.gov.
Audio of the teleconference will stream live on the agency’s website.
9:10 p.m. – Launch coverage begins on NASA+ and the agency’s website.
9:29 p.m. – Launch
Tuesday, Nov. 5:
8:45 a.m. – Arrival coverage begins on NASA+ and the agency’s website.
10:15 a.m. – Docking
NASA website launch coverage
Launch day coverage of the mission will be available on the NASA website. Coverage will include live streaming and blog updates beginning no earlier than 9:10 p.m., Nov. 4, as the countdown milestones occur. On-demand streaming video on NASA+ and photos of the launch will be available shortly after liftoff. For questions about countdown coverage, contact the NASA Kennedy newsroom at 321-867-2468. Follow countdown coverage on our International Space Station blog for updates.
Attend Launch Virtually
Members of the public can register to attend this launch virtually. NASA’s virtual guest program for this mission also includes curated launch resources, notifications about related opportunities or changes, and a stamp for the NASA virtual guest passport following launch.
Quelle: NASA
----
Update: 2.11.2024
.
NASA instrument to study the mysterious origins of the solar wind
By creating artificial eclipses, CODEX will track bursts of charged particles that stream from the Sun

An instrument attached to the International Space Station will study the “middle corona,” a region of the Sun’s atmosphere where charged particles get heated and sped up.KOREA AEROSPACE ADMINISTRATION/KOREA ASTRONOMY AND SPACE SCIENCE INSTITUTE
For a few precious minutes during a solar eclipse, the Moon blots out the disk of the Sun, revealing its wispy outer atmosphere, or corona. On 4 November, NASA plans to launch the Coronal Diagnostic Experiment (CODEX), an instrument that will create eclipses on demand with a Sun-blocking device called a coronagraph. Attached to the International Space Station (ISS), it will study the “middle corona,” the layer of the Sun’s atmosphere that generates the solar wind, the stream of charged particles—mostly electrons—that fan out from the Sun toward Earth.
By consistently measuring the solar wind’s temperature and speed in this region for the first time, CODEX scientists hope to improve their understanding of what accelerates and heats it up–and what sometimes causes highly energetic bursts of particles to crash into Earth in bouts of space weather.
CODEX will provide “a level of detail that we’ve never been able to have before,” says Nicholeen Viall, a heliophysicist at NASA’s Goddard Space Flight Center and the science lead on CODEX, a $30 million collaboration between NASA, the Korea Astronomy and Space Science Institute (KASI), and Italy’s National Institute for Astrophysics.
Around the world, a suite of instruments already study the Sun’s corona from the ground and space. Perhaps most notable is NASA’s Parker Solar Probe, which in 2021 became the first spacecraft to fly through the corona. But Parker samples the outermost parts of the corona at a distance of about 10 solar radii, whereas other solar telescopes zoom in on its innermost parts. CODEX will target the middle corona, between about 2.75 and 10 solar radii.
CODEX will observe the solar wind not just in a new place, but in new ways. Most coronagraphic instruments measure the overall brightness of the light reflected by electrons in the solar wind, which corresponds to the density of particles and the wind’s strength.
But CODEX’s coronagraph, which blocks the Sun with a disk as wide as a tennis ball, will also measure the speed and temperature of the electrons, using four filters that gather coronal light at specific wavelengths. Changes in particle temperature alter the shape of the corona’s spectrum—the intensity of the light at a given wavelength. With the filters sampling four points on this spectrum, CODEX researchers can estimate its shape and work backward to calculate the temperature of the particles.
To calculate speed, CODEX researchers will measure shifts in the four filtered wavelengths caused by electrons moving toward or away from Earth. The shifts occur because of the Doppler effect—the same reason ambulance sirens squeal higher on approach and shift down in pitch as they recede.
The measurements could help heliophysicists solve an enduring mystery: the mechanisms that heat the solar wind to more than 1 million degrees Celsius and speed it up to more than 1 million kilometers per hour. Those have been “key outstanding problems in solar physics for decades,” says Jeffrey Newmark, a heliophysicist at Goddard and principal investigator (PI) of CODEX. “We’re going to add pieces to the puzzle.”
There are two leading theories, both involving the conversion of the Sun’s magnetic energy into the thermal energy of the solar wind particles. One suggests that as tangled and looping magnetic fields reconnect near the Sun’s surface, they release bursts of energy into the corona that excite the solar wind particles until they overcome the Sun’s gravity. Another theory posits that the wiggling of Alfvén waves, oscillations in the Sun’s magnetic field that penetrate into the corona and turn back on themselves, can also inject energy into the solar wind. However, these theories aren’t mutually exclusive; both mechanisms likely occur, Viall says.
Most of the time, Earth’s magnetic field can rebuff and deflect the solar wind. But sometimes, bouts of intense magnetic activity on the Sun lead to coronal mass ejections—high-powered, bloblike bursts of solar wind. These space weather events can cause visually stunning aurorae when they crash into Earth’s magnetic field, but the energetic particles can harm astronauts, disrupt satellite operations, and interfere with utility power grids. Collecting more data should help heliophysicists inch closer to predicting space weather events much like meteorologists forecast hurricanes, Viall says.
However, CODEX’s location on the ISS means it can only catch space weather events when it happens to be oriented toward the Sun—roughly a bit more than half the time, says Yeon-Han Kim, a solar astronomer at KASI and PI of South Korea’s CODEX team.
Another payoff of missions like CODEX is their ability help heliophysicists understand other stars in the universe, says Christina Cohen, a space physicist at the California Institute of Technology who is not involved with CODEX. “People who study the Sun, like me, like to think of our Sun as special,” she says. But it’s actually a fairly common kind of star, and “anything we can really understand should apply to at least a certain category of stars,” she says.
In the coming year, NASA and the European Space Agency plan to launch more coronagraphic missions to study the Sun’s corona and solar wind, including PUNCH (Polarimeter to Unify the Corona and Heliosphere) and Proba-3. Cohen is pleased. “The more, the better,” she says.
Quelle: AAAS
----
Update: 5.11.2024
.
On Monday, November 4 at 9:29 p.m. ET, Falcon 9 launched Dragon’s 31st Commercial Resupply Services mission (CRS-31) to the International Space Station from Launch Complex 39A at NASA’s Kennedy Space Center in Florida. Following stage separation, Falcon 9’s first stage landed at Cape Canaveral Space Force Station Landing Zone 1.
Dragon autonomously docked with the space station on Tuesday, November 5 at 9:52 a.m. ET.






































Quelle: SpaceX
